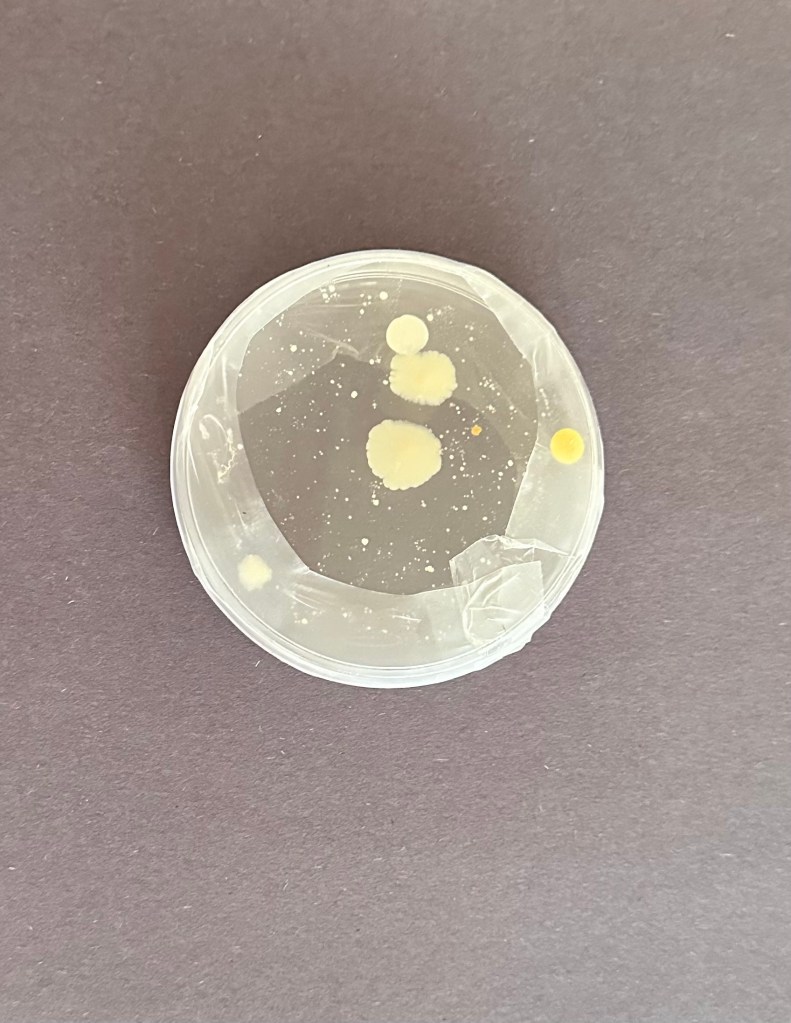

The Process
Project Details:
My science fair project aimed to assess the effectiveness of nano-hydroxyapatite (nHA) in preventing tooth decay and mitigating staining caused by common dietary factors. Conducted through procedures, including pH measurements of various beverages and immersion of artificial teeth, the study demonstrated promising outcomes. Teeth treated with nano-hydroxyapatite showed reduced staining and maintained their integrity better than untreated teeth, particularly in acidic environments. The coated petri dishes exhibited decreased bacterial proliferation, suggesting the material’s potential in preventive dental care. These findings underscore nano-hydroxyapatite’s role in enhancing dental health practices, with implications for addressing oral health disparities globally. However, limitations regarding experimental design and oral microbiome dynamics warrant further research to optimize nHA’s application in mainstream dental care practices.
© 2024 by AIM Forever.